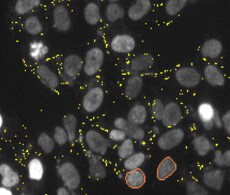
hcs-apoptosis-caspase-assay-banner hcs-apoptosis-caspase-assay-banner

Search
Search
筛查支原体污染是每个开展细胞培养的实验室必须进行的检测。培养细胞被支原体污染后会改变细胞生理性质,影响实验结果。支原体污染无法通过肉眼检查细胞来发现,也不能通过向培养基中加入抗生素控制。常规的检测方法包括PCR和酶活性测定,这些方法需要花费大量的金钱或时间,而且灵敏度和特异性不一。
使用高内涵筛选和明场图像检测细胞培养物中的支原体污染,可以快速、自动化检测和定量分析细胞内的核外DNA。根据组织细胞人工培养协会推荐的支原体检测程序 (TCA第75361号程序),用适当的容器 (如96孔板、腔室玻片) 培养细胞,然后用Hoechst染色 (Hoechst可与dsDNA结合),并检查细胞培养体系中有无大小均匀的核外DNA。
应用ArrayScan 高内涵筛选系统进行明场和荧光多模式成像,可以使支原体检测成为自动化的常规程序,用于监测实验室中细胞培养的质量。明场图像用于对细胞内支原体的位置进行视觉确认。通过将明场通道与所有包含DNA染料Hoechst的高内涵分析结合,每次进行ArrayScan分析时都可以快速检测的方式进行支原体检测和定量。
用目标基因转染HeLa细胞。使用DMEM (含高糖)、L-谷氨酰胺 (2 mM)、丙酮酸钠 (1 mM)、10% FBS和G418 (0.3 mg/mL) 培养细胞,添加或不添加青霉素-链霉素。本研究所用细胞均处于传代15至18次之间。将细胞按照每孔5,000个细胞的密度接种于96孔板上,每孔100 μL培养基。加板盖后放入培养箱中过夜,使细胞贴壁。第二天向每孔加入10 μL Hoechst 33342 (终浓度2 μg/mL,Invitrogen)。用100 μL PBS洗涤一次细胞,分析前向每孔中加入100 μL PBS。使用ArrayScan 及明场采集图像,并使用 Compartmental Analysis BioAppliaction进行图像分析。

图1:对存在支原体污染的HeLa细胞进行多模式图像采集
图1显示了使用ArrayScan 和明场模块拍摄的被支原体污染的HeLa细胞图像,并使用Compartmental Analysis BioApplication进行图像分析。图A和B为同一视野图像,图C和D为图A中白框内图像的放大图。图A和C显示了经Hoechst 33342染色的细胞核以及通过Compartmental Analysis BioApplication识别的核外DNA (黄色图层信号)。图B和D为同一明场图像,以及通过BioApplication在Hoechst通道识别的支原体图层信号 (标记为红点)。

图2:对未被污染的HeLa细胞进行DNA Hoechst染色,并对细胞外DNA进行定量检测
ArrayScan 的多模式功能使用户可以确认核外DNA是整个细胞的一部分还是培养基中存在细胞外支原体 (如图2中C和D所示)。尽管Hoechst染色后用PBS洗涤过培养孔,但视野内仍存在细胞外支原体,如图C和D中红色箭头所示。图C为Hoechst染色,其中蓝色图层信号标注的为细胞外DNA,图D所示明场图像显示没有细胞带有Hoechst阳性染色。在图2的A和B中,HeLa细胞核外或细胞外均无Hoechst染色。图A为Hoechst染色,蓝色叠加线表示分析目标,图B为Hoechst通道图像,如果存在核外DNA,则会在该图中显示。

图3:在细胞水平对正常HeLa细胞群体和污染群体的Hoechst 33342染色进行分析
根据PCR产物琼脂糖凝胶电泳结果(未展示),确认存在支原体污染。图3的图表显示核外点计数超过临界值的细胞百分比,并通过正常HeLa细胞百分比进行标准化。